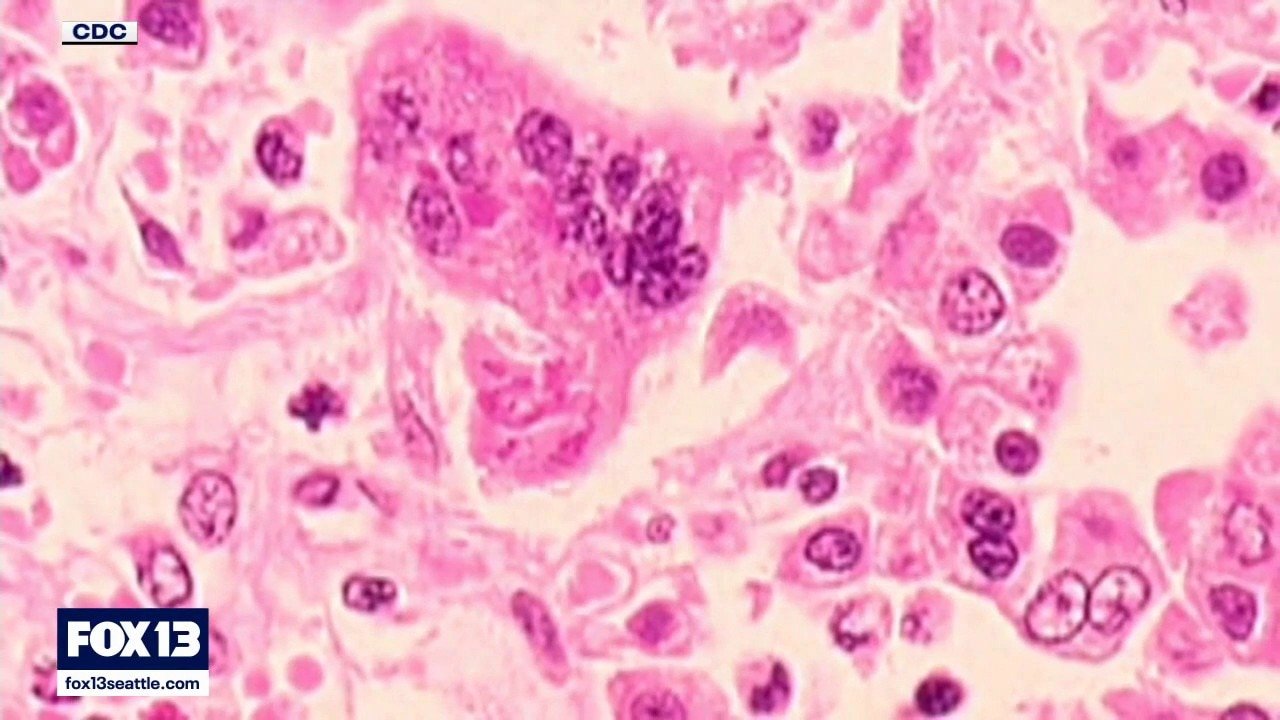

Snohomish County measles outbreak grows to six cases, health officials say
Snohomish County health officials confirmed three new measles cases, bringing the outbreak total to six and prompting renewed calls for vaccination.
Top Videos
Snohomish County measles outbreak grows to six cases, health officials say

Body recovered at Haller Lake in North Seattle

US and Iran reach agreement to end war

Deadly I-90 crash causes two-mile backup

Police increase DUI patrols for Seattle World Cup

Thousands cross the purple carpet at UW graduation

Fighter jet crash sparks wildfire near Yakima

World Cup action kicks off in Seattle on Monday

Good Day Seattle for Sunday, 6/14

Seattle News Tonight for Saturday, 6/13

Seattle launches new way to save at local restaurants

Good Day Seattle for Saturday, June 13

New World Cup tech aims to fix offside reviews

DNA evidence leads to arrest in Marysville jewelry heist

First look at Seattle Seahawks Super Bowl rings

Trump still optimistic on peace deal with Iran

Seattle News Tonight for Friday, 6/12

Washington News Wrap for Friday, 6/12

Seattle reacts to USA dominating Paraguay in World Cup

Severe storms, tornadoes hit the Midwest

The Spotlight: ‘Onlyfans house’ raided in Bellevue, WA

Seattle Center transforms for the World Cup

Officials warn of dangerous waters during heat wave

Firefighters prepare for wildfires amid record heat

SpaceX weighs future of data center satellites
